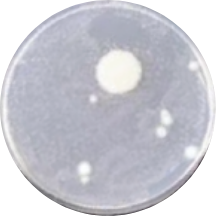
バクテリア
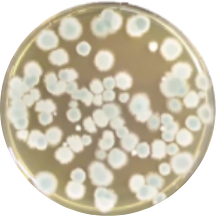
カビ菌

食品売場を
清潔に保つ
清潔に保つ

皆様が毎日買い物をしている、スーパーや コンビニ。
その食品売場の冷蔵ショーケースが、
カビやバクテリアの温床になっていることをご存知でしょうか?
驚くべきことに、多くの店舗で適切な清掃が行われておらず、
業界全体としても抜本的な対策が取られていないのが現実です。
この深刻な衛生リスクは、今もなお放置されたまま。
私たちは、日常の「当たり前」の裏側にあるこの問題に向き合い、
“知られざる社会課題”の解決を目指しています。
その食品売場の冷蔵ショーケースが、
カビやバクテリアの温床になっていることをご存知でしょうか?
驚くべきことに、多くの店舗で適切な清掃が行われておらず、
業界全体としても抜本的な対策が取られていないのが現実です。
この深刻な衛生リスクは、今もなお放置されたまま。
私たちは、日常の「当たり前」の裏側にあるこの問題に向き合い、
“知られざる社会課題”の解決を目指しています。
実は不衛生な
食品売り場
皆様が日々、
食材を手に取っているスーパーやコンビニ。
実はその食品売場の冷蔵ショーケースが、
長年にわたり清掃されず、カビやバクテリアの
温床となっていることをご存じでしょうか?
食材を手に取っているスーパーやコンビニ。
実はその食品売場の冷蔵ショーケースが、
長年にわたり清掃されず、カビやバクテリアの
温床となっていることをご存じでしょうか?
食品売場は、本来“最も清潔であるべき場所”のはず。
それにもかかわらず、汚れは見えない場所に蓄積し、
気づかれないまま、10年近く放置されているケースもあります。
それでも、この問題に正面から向き合う企業は、
いまだ皆無と言っていい状況です。
それにもかかわらず、汚れは見えない場所に蓄積し、
気づかれないまま、10年近く放置されているケースもあります。
それでも、この問題に正面から向き合う企業は、
いまだ皆無と言っていい状況です。
食品ショーケースから検出された
カビ、バクテリア
カビ、バクテリア
(大阪産業技術研究所調べ)
バクテリア
カビ菌
冷蔵ショーケースの仕組み


冷蔵ショーケースの上部には、「ハニカム」と呼ばれる部品があります。
このハニカムは、冷気の流れを整え、ショーケースの前面に“エアーカーテン” を形成することで、冷気を外に逃がさない役割を担っています。しかし、この重要な部品は、その構造上、ホコリや油分が付着しやすいにもかかわらず、清掃がほとんど行われていません。長年放置されたハニカムには、汚れが層のように堆積し、目詰まりを起こすことで、カビやバクテリアが繁殖する温床となってしまいます。さらに問題なのは、目詰まりによって冷却効率が大きく損なわれるという点です。ショーケースメーカーの試算では、汚れたハニカムがあるだけで、冷蔵ショーケースは年間で約10%もの電力を余分に消費していることがわかっています。

知られざる
社会課題を
解決する
私たちInnoBEEtionsは、こうした問題に対して、
清掃に頼らず、“汚れを防ぐ”という発想から生まれた新しいソリューションを開発しました。
それが、特許取得の「ハニカム抗菌シートⓇ」です。
冷蔵ショーケースのハニカム部に取り付けるだけで、ホコリや異物の付着を防ぎ、
カビやバクテリアの繁殖リスクを抑制。
1年に一度のシート交換だけで、ハニカムを常に清潔な状態に保つことができます。
清掃の負担をなくし、衛生的で、そしてエネルギー効率の高い売場をつくる。
ハニカム抗菌シートⓇは、食品流通業界に
新しいスタンダードをもたらすソリューションです。
清掃に頼らず、“汚れを防ぐ”という発想から生まれた新しいソリューションを開発しました。
それが、特許取得の「ハニカム抗菌シートⓇ」です。
冷蔵ショーケースのハニカム部に取り付けるだけで、ホコリや異物の付着を防ぎ、
カビやバクテリアの繁殖リスクを抑制。
1年に一度のシート交換だけで、ハニカムを常に清潔な状態に保つことができます。
清掃の負担をなくし、衛生的で、そしてエネルギー効率の高い売場をつくる。
ハニカム抗菌シートⓇは、食品流通業界に
新しいスタンダードをもたらすソリューションです。
ハニカムの衛生管理がもたらす、社会的インパクト
-
年間電気代削減額290 億円日本中の食品小売業がハニカムを清潔に保つことで、年間290億円の電力コスト削減が実現できます。
-
CO2の削減40.3 万tCO2排出量の削減にも寄与し、年間40.3万トンの温室効果ガスの削減が可能です。
-
日本のCO2削減目標
に対する寄与1.04 %これは、政府が掲げる2030年の温室効果ガス削減目標(6,440万トン)の1.04%に相当するインパクトです。
※当社試算に基づく
算出条件:電力購入量=39,983百万kWh、食品小売業売上=30兆円、CO2排出係数=0.463kg-CO2/kWh、電力単価=20円/kWh ほか
算出条件:電力購入量=39,983百万kWh、食品小売業売上=30兆円、CO2排出係数=0.463kg-CO2/kWh、電力単価=20円/kWh ほか
清潔で、省エネな売場に。
冷蔵ショーケースの
新しいスタンダード。

ハニカムの清掃不要、省エネと衛生管理も同時に実現。
食品売場の新しいスタンダード。
食品売場の新しいスタンダード。
ハニカム抗菌シートⓇは、冷蔵ショーケースの「ハニカム」に取り付けるだけで、常に清潔な状態を維持できる抗菌シートです。ホコリや異物の付着を防ぎ、カビやバクテリアの繁殖リスクも低減。さらに、目詰まりによる冷却効率の低下を防ぐことで、省エネにもつながります。メンテナンスは、定期的なシート交換のみ。現場の清掃負担を減らしながら、清潔な売場と環境への配慮を両立できる、新しい選択肢です。


ハニカム抗菌シートⓇで得られる3つの効果
-
清掃不要で、
衛生管理がラクに。ハニカムに設置するだけで、ホコリや異物の付着を防止。
カビやバクテリアの繁殖リスクを抑え、清掃いらずで衛生状態をキープできます。面倒なハニカムの掃除は、もう必要ありません。 -
電気代を年間5〜10%削減。
実質コストゼロ。目詰まりを防ぎ、冷却効率を維持することで、ショーケースの電力消費を大幅カット(5~10%削減)。
節電額の範囲内で導入できるため、実質的な費用負担なく導入が可能です。
※ショーケースメーカー発表数字 -
お客様に安心される、
清潔な売場づくり。ハニカム抗菌シートⓇの導入は、店舗の“目に見えない汚れ”にもきちんと対処している証。見えない部分にまで気を配る姿勢は、お客様に本当の安心と安全を届け、その在り方が、選ばれる売場をつくっていきます。
最新情報
-
 2026.2.10見えない課題に、どう向き合うか詳しく見る
2026.2.10見えない課題に、どう向き合うか詳しく見る -
 2026.1.16なぜ、ハニカムの汚れは問題として扱われなかったのか詳しく見る
2026.1.16なぜ、ハニカムの汚れは問題として扱われなかったのか詳しく見る -
 2026.1.14ハニカムって、どのぐらい汚れているの?詳しく見る
2026.1.14ハニカムって、どのぐらい汚れているの?詳しく見る






